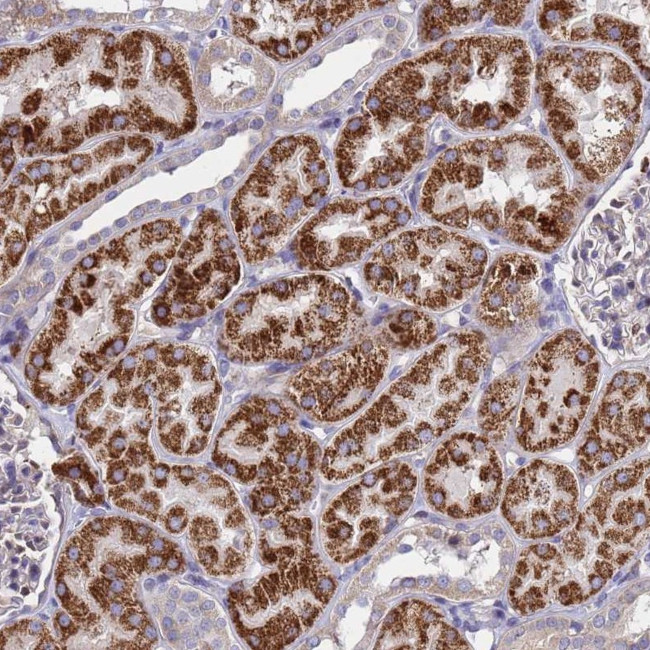
GCP3 Antibody in Immunohistochemistry (Paraffin) (IHC (P))

Search
Invitrogen
GCP3 Polyclonal Antibody
{{$productOrderCtrl.translations['antibody.pdp.commerceCard.promotion.promotions']}}
{{$productOrderCtrl.translations['antibody.pdp.commerceCard.promotion.viewpromo']}}
{{$productOrderCtrl.translations['antibody.pdp.commerceCard.promotion.promocode']}}: {{promo.promoCode}} {{promo.promoTitle}} {{promo.promoDescription}}. {{$productOrderCtrl.translations['antibody.pdp.commerceCard.promotion.learnmore']}}
产品信息
PA5-60549
种属反应
宿主/亚型
分类
类型
抗原
偶联物
形式
浓度
规格
纯化类型
保存液
内含物
保存条件
运输条件
RRID
产品详细信息
Immunogen sequence: LLSVLHSQLQ LEDDQGVNLG LESSLTLRRL LVWTYDPKIR LKTLAALVDH CQGRKGGELA SAVHAYTKTG DPYMRSLVQH ILSLVSHPVL SFLYRWIYDG ELEDTYHEFF VASDPTVKT
Highest antigen sequence identity to the following orthologs: Mouse - 99%, Rat - 98%.
靶标信息
The gamma-Tubulin complex is composed of gamma Tubulin and the gamma-Tubulin complex associated proteins GCP2, GCP3, GCP4, GCP5 and GCP6, all of which are essential components of microtubule organizing centers. gamma-Tubulin complex components are localized to both the centrosome, where they are involved in microtubule nucleation, and to the cytoplasm, where they exist as soluble complexes that can be recruited to the centrosome as needed. Although the GCP proteins are related, they have distinct roles which contribute to the proper function of the gamma-Tubulin complex. GCP3 (gamma-tubulin complex component 3), also known as TUBGCP3 or SPBC98, localizes to the centrosome and is an ubiquitously expressed 907 amino acid member of the gamma-Tubulin complex.
仅用于科研。不用于诊断过程。未经明确授权不得转售。
篇参考文献 (0)
生物信息学
蛋白别名: component of cytoplasmic gamma-tubulin complex; Gamma-ring complex protein 104 kDa; Gamma-tubulin complex component 3; GCP-3; h104p; hGCP3; hGrip104; hSpc98; Spindle pole body protein Spc98 homolog; tubulin gamma complex associated protein 3; unnamed protein product
基因别名: 104p; ALP6; GCP3; Grip104; SPBC98; Spc98; Spc98p; TUBGCP3
UniProt ID: (Human) Q96CW5
Entrez Gene ID: (Human) 10426